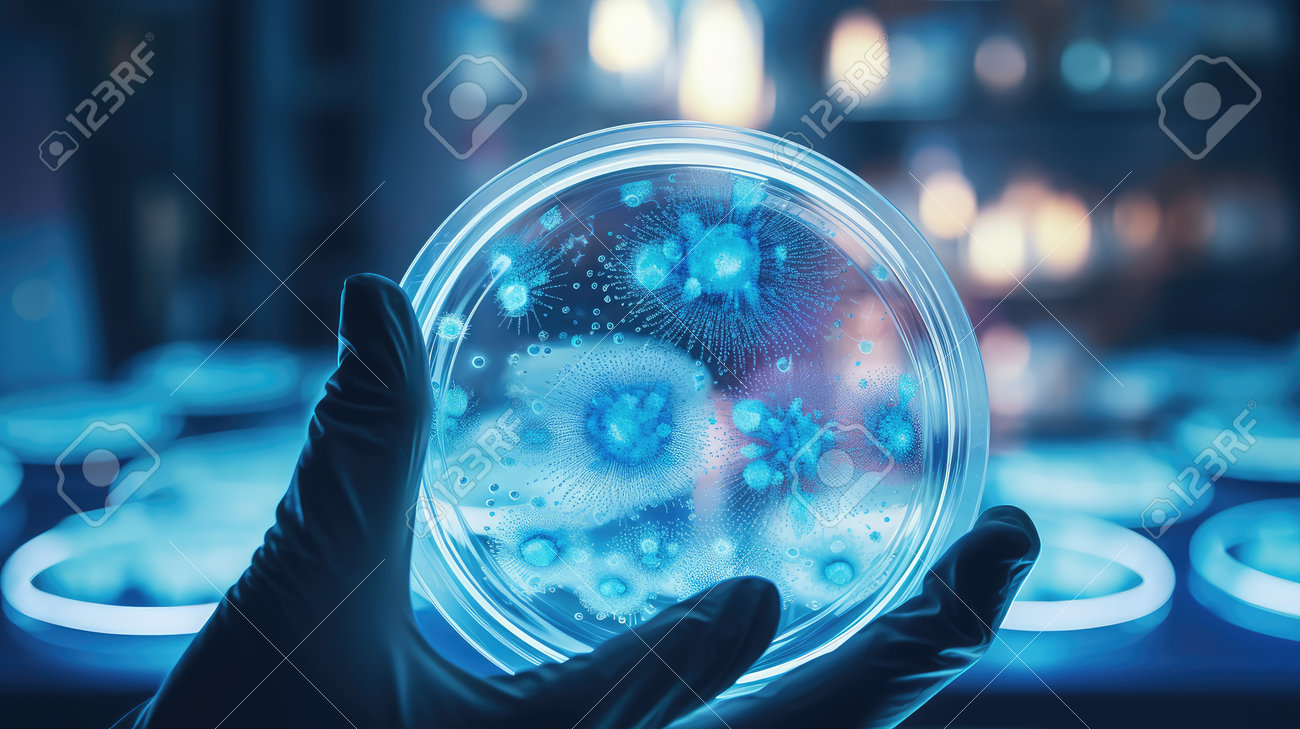
etiam-dictum-ipsum-a-felis

Download
Close
Автор:
id:
Ключевые слова:
agar, analysis, assay, bacteria, biohazard, blue, coat, colonies, contamination, culture, diagnostics, dish, experiment, germ, growth, identification, illustration, incubation, infection, isolation, lab, laboratory, medium, microbiology, microorganism, observation, pathogen, petri, research, sample, scientist, specimen, sterile,





